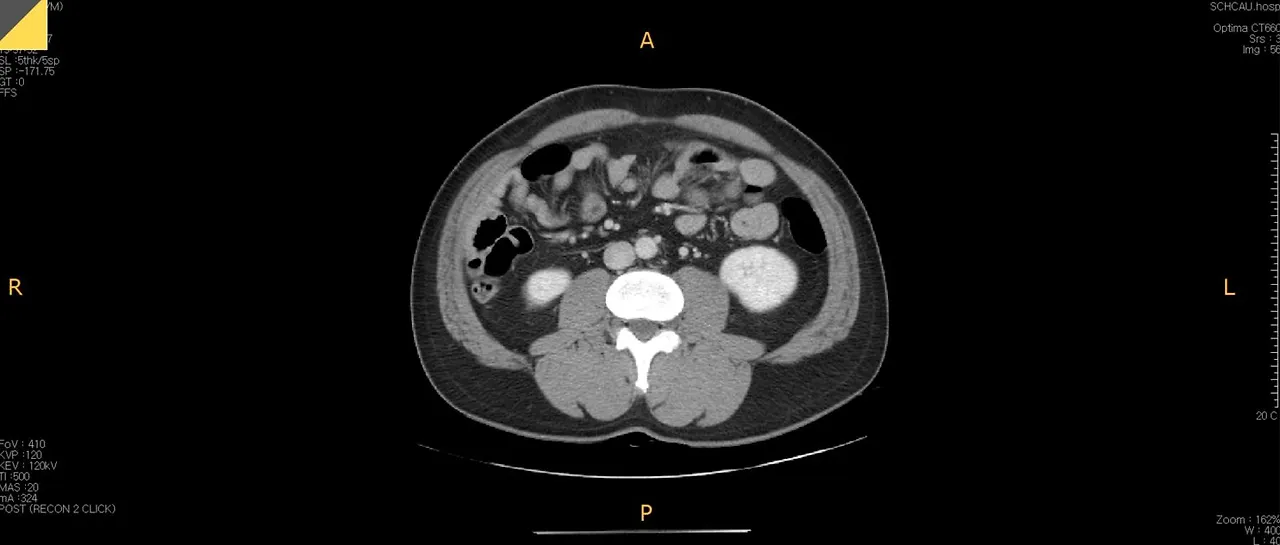
복부CT.JPG

남자들이 나이들면 배가 나오는 이유?
by 배뚱뚱이
 언뜻 봐도 슬림해 보이지 않는 배뚱뚱이의 복부 CT 사진
언뜻 봐도 슬림해 보이지 않는 배뚱뚱이의 복부 CT 사진시작부터 깜짝 놀랄 그림 하나 보여드리고 시작합니다. 이 사진은 배뚱뚱이가 지난 8월에 배탈이 나서 찍은 복부 CT 사진입니다. 언뜻 봐도 슬림해 보이진 않네요. 오늘의 주제는 바로 이 부분, 뱃살입니다.
# 같은 듯 다른, 내장지방과 피하지방
 빨간 부분은 피하지방, 하얀 부분은 내장 지방
빨간 부분은 피하지방, 하얀 부분은 내장 지방위의 CT 우측 반을 확대해서 표시를 해봤습니다. 하얀색으로 테두리 쳐진, 배 근육 안에 존재하는 지방들이 내장지방이고 바깥에 빨간색으로 테두리 쳐진 부분이 피하지방입니다. 사실 저는 살이 찔 때마다 피하지방보다는 내장지방이 걱정이었는데, 이번에 사진을 찍고 보니 등에 있는 살이 이렇게 많은 줄 처음 알았습니다. 저는 피하지방은 별로 없고 내장지방이 문제인 것으로 알고 있었거든요.

참고로 이건 제 허벅지 사진입니다. 여기에는 표시하지 않았지만 제 허벅지 한쪽의 지름은 약 22cm 정도 되고 보시면 근육이 대부분이고 살이 별로 없는 것처럼 보입니다. 그래서 ‘나는 피하지방은 괜찮아~’라고 생각했는데 이번에 찍은 CT에서는 그게 아닌 것이 밝혀졌습니다. (허리살이요ㅠㅠ)
# 내장지방 나빠요~
체중 감량에 한 번이라도 도전해 본 사람이라면 내장지방과 피하지방을 들어봤을 겁니다. 이번 글을 준비하며 좀 더 자세히 찾아봤는데, 재미있는 논문 하나를 발견해 이 내용을 중심으로 소개해드리려 합니다. (김재범 외, Distinct properties of adipose stem cell subpopulations determine fat depot-specific characteristics Cell Metabolism, March, 2022; 34(3) https://www.sciencedirect.com/science/article/abs/pii/S1550413121005428 )
내장지방과 피하지방은 서로 다른 기능을 수행할 것으로 추정됩니다. 하지만 정확히 알려진 바는 없다고 합니다. 다만 이 지방들이 생성하기 시작하게 하는 지방조직의 줄기세포는 서로 다른 기능을 보인다고 합니다. 내장지방의 줄기세포군은 지방조직 증가와 염증반응 및 섬유화를 촉진해 궁극적으로는 대사질환(당뇨, 고혈압)등을 유도합니다. 반면에 피하지방의 줄기세포군은 에너지 소비를 촉진하고 염증반응을 억제하고, 피하지방이 건강한 지방조직으로 기능하도록 작용한다고 합니다. 어려운 말을 늘어놨지만 언뜻 봐도 내장지방이 나빠 보이죠?
어느 부위의 지방이 먼저 살이 찌는지는 유전적인 정보에 엄청나게 의존하기 때문에 설명하기는 어렵습니다. 미국에 가보면 얼굴은 전혀 살이 없고 작은데 골반 중심으로 엄청난 초 고도 비만인 사람이 있는 반면, 우리나라는 라면만 먹어도 얼굴부터 살이 찌는 사람이 많죠. 그래서 살이 찔 때 어디가 먼저 찔지를 예측하는 것은 쉽지 않습니다.
# 내장지방과 피하지방? 식사의 퀄리티가 중요
사실 아직 완벽하게 밝혀진 것은 아니지만, 내장지방은 피하지방에 비해서는 먹는 것의 퀄리티에 영향을 더 받는 것 같습니다.
음주
단순당, 과당의 과다 섭취
폭식
체중조절의 반복
이 정도가 상대적으로 내장지방에 살이 더 많이 찌는 원인이라고 하는데, 단 것 많이 먹고, 빵 많이 먹고 술 마시고 야식하면… 네 그 이상은 생략하겠습니다. 결국 앞서 말한 것처럼 단순히 살이 찌는 것뿐만 아니라 몸이 나빠지는 호르몬들을 뿜어내는 것이 바로 내장지방입니다. 건강한 식생활은 내장 지방뿐만 아니라 전신에 좋은 영향을 줍니다.
# 다행히! 내장지방부터 빠집니다.
내장 지방은 식사에서 쌀밥, 과자, 밀가루만 줄이고 운동을 하면 우리 몸에서 가장 빠르게 빠지는 지방입니다. (참 쉽죠?^^) 그래서 내장지방은 우리가 알고 있는 모든 다이어트 방법을 하면 빠지기 시작합니다. 우리가 살을 뺄 때 뱃살은 전혀 줄어든 것 같지 않은데, 바지의 허리둘레가 줄어드는 것을 가끔(가~~~~끔) 경험할 때가 있습니다. 그건 우연과 착각이 아닌 내장지방이 가장 먼저 소비되기 때문입니다. 어찌 보면 체중을 보지 말고 눈바디(눈으로 보는 체형)를 보라는 얘기가 허언이 아닌 것 같습니다. 밖에서 잡히는 살은 별 변화가 없더라도, 내 몸의 변화는 안에서는 이미 변화가 일어나고 있는 것이죠.

# 운동으로 빠지지 않는 피하지방, 결국 식이조절
피하지방은 단순히 살의 양뿐만 아니라 미용적 관점에서 매우 문제가 되는 살입니다. 옆구리, 뒷구리, 팔뚝살, 늘어지는 모든 살들은 전부 다 피하지방입니다. 그리고 이 살들을 별도로 뺄 수 있는 운동은 없습니다. 다만 주변 근육을 강화해 그 주변 피부 (슬프게 말하자면 지방 껍데기)를 조금 탄력 있게 하는 것으로 시각적인 착시 효과를 줄 수 있습니다. 하지만, 결국 지방의 양을 줄이려면 더 많은 식이조절이 필요합니다. 피하지방은 인바디가 아닌, 스킨폴드 캘리퍼(아래 그림) 로 측정을 합니다. 말 그대로 살이 얼마나 튀어나와 있어서 얼마나 찝히는지를 알 수 있는 도구입니다. 이 도구는 아무 데나 잡아서 측정하는 것이 아니라 크게 세 군데 남자는 허벅지, 배, 가슴 여자는 배, 팔뚝살, 허벅지를 측정합니다.
살을 빼기 시작하면 피하 지방도 당연히 조금은 빠집니다. 하지만 늘어져 있는 정도의 피하지방을 깔끔하게 빼기 위해서는 흔히 말하는 바디 프로필을 찍는다는 느낌으로 온몸의 전체 살을 말리는 정도의 노력이 있어야 한다고 합니다. 즉, 꽤 긴 기간 동안 지속적인 체중 감소가 있어야 합니다. 내장 지방에서 더 이상 빠질 것이 없다고 몸이 인식을 해야 그다음에 피하 지방도 소모하기 때문입니다. 그리고 피하 지방 안에서도 엉덩이와 다리의 지방이 복부의 피하지방보다도 지방산을 토하는 정도 즉, 지방을 줄이는 것이 가장 느리다고 합니다. 그나마 피하지방 중에서는 배가 가장 먼저 빠지는 것이 다행이라고 할까요? ^^

# 그런데, 내장지방이고 피하지방이고… 나이가 들으면 왜 자꾸 배만 살이 찔까?
특히 남성 분들이 많이 가지는 의문점입니다. 왜 중년 남자들은 배부터 살이 찔까요? 저도 이제 나이가 40대 중반이 되다 보니… 늘 걱정하는 부분입니다. 그 부분에 대해서는 2개의 호르몬으로 설명을 드릴 수 있습니다.
1.여성호르몬의 역할이 적습니다. (남성 한정)
여성호르몬은 신기하게도 복부에 갈 지방을 허벅지 쪽에 더 많이 쌓이게 한다고 합니다. 당연히 여성호르몬이 적은 남성의 경우 당연히 살이 찔 때 1차 타깃이 되는 부분이 배가 되는 것입니다.
2.모든 호르몬이 줄어들기 시작합니다. (여자, 남자 공통)
우리 몸의 신체 기능의 최정점은 학자에 따라 다르지만 보통 25세 이후로 보는 것이 정설입니다. 그 이후부터는 조금씩 조금씩 근육 양이 줄어들기 시작하고 몸은 늙기 시작합니다. 아마 많은 분들이 ‘기초 대사량’이라는 말을 들어보셨을 것입니다. 그 기초 대사량을 결정하는 식의 x값이 결국 근육량이라서 근육량이 줄어들면 기초 대사량은 당연히 따라서 줄어듭니다. 결국, 같은 밥을 먹어도 칼로리가 남게 되어 살로 가게 되는 거죠.
그런데 이 일반적인 변화에서 가속 페달을 밟는 시기가 있는데 바로 <갱년기>입니다. 여성은 폐경이라는 큰 신체적 변화가 명확히 오기 때문에 잘 알아차릴 수 있지만 남자들은 본인이 갱년기라는 것을 잘 알지 못합니다. 하지만 남자도 40대 중반 이후부터는 테스토스테론 등 남성 호르몬이 떨어집니다. 이전 도핑 글에서도 소개드렸지만, 기본적으로 남성 호르몬은 근육을 키우는 원동력이 되는 호르몬입니다. 그 남성 호르몬이 줄어들면서 근육량의 감소가 빠르게 일어나고, 그에 따라 기초대사량도 빠르게 감소해 예전처럼 밥을 먹다가는 살이 찌는 황당한 일이 일어나는 것입니다.

# 뱃살을 걱정하는 중년을 위해!
제가 글을 적고 보니… 뭔가 슬픈 얘기만 잔뜩 적어 놓은 것 같습니다. 사실 저도 이제 40대 중반이기 때문에 위와 같은 신체적 변화를 겪기 시작할 나이가 되었거든요. 제가 운동 관련해서 가장 많이 보는 블로거인 수피 (blog.naver.com/kiltie999)라는 분의 블로그에 나오는 내용을 제가 조금 각색해서 우리가 앞으로 나아갈 바를 정리해볼까 합니다.
1.40대가 넘어가면 체지방 한자리 %는 어렵고, 남자는 13~15% 여자는 20~24% 정도만 되어도 현실적으로 건강한 몸매라 할 수 있다.
2.좋은 것을 챙기자 보다는 ‘나쁜 걸 빼자’가 우선이다
3.식사관리 안 되면 아무것도 안 된다! (특히 내장지방의 경우 식생활이 가장 큰 영향을 미칩니다.)
4.본인의 원래 섭취 열량에서 10~15% 만 꾸준히 줄여 먹는다. 특히 당뇨, 대사증후군이 있다면 이것이 가장 긍정적이다.